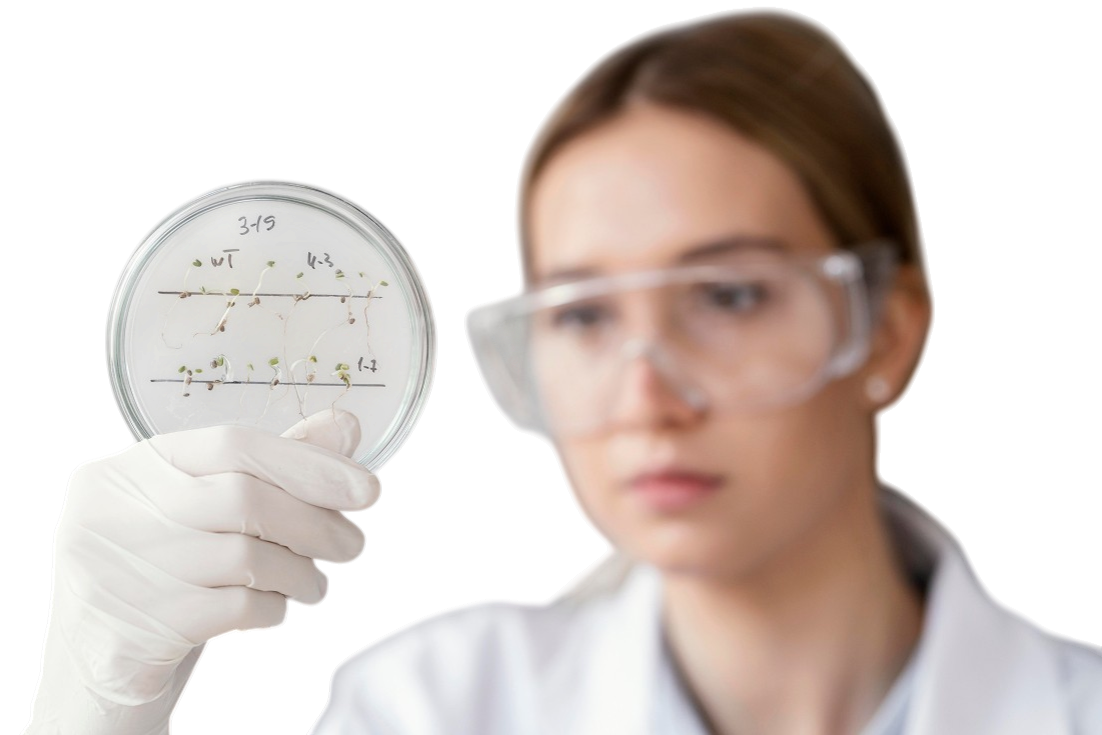
Генетический анализ гемостаза (4 показателя) в Москве

Генетический анализ гемостаза
(4 показателя)
в Москве
Клиника Hormone Life — профессиональная лабораторная диагностика. Генетический анализ гемостаза (4 показателя): точность, скорость, конфиденциальность.
- Результат за 1 день
- Безболезненно
- Конфиденциально

Что показывает анализ
Количественный показатель
Точное числовое значение в единицах СИ. Результат сравнивается с референсным диапазоном лаборатории.
Референсные значения
Норма для вашего возраста и пола. Отклонения от референса требуют консультации специалиста.
Интерпретация
Врачебный комментарий к результату. Наш эндокринолог объяснит значение каждого показателя.
Динамика показателя
Контроль изменений при повторном исследовании. Динамика помогает оценить эффективность лечения.
Как проходит исследование
Процедура занимает не более 10 минут и состоит из трёх простых шагов:
ЗАПИСАТЬСЯПодготовка
Чтобы результат был достоверным, придерживайтесь простых правил:
Натощак
последний приём пищи за 8–12 часов до анализа
Утреннее время
кровь сдаётся строго до 11:00, в это время концентрация показателей максимальна
Покой
за 24 часа исключите тяжёлые тренировки, алкоголь и стрессы. За 1 час — не курите
Забор материала
Процедура
быстрый и практически безболезненный забор крови из вены
Безопасность
используем только стерильные одноразовые вакуумные системы
Срок готовности
Результат
через 1 рабочий день (не считая дня забора)
Где получить
пришлём PDF-отчёт на электронную почту, в личный кабинет или выдадим распечатку в центре
Врачи, которые работают с результатами
Более 10 лет опыта за плечами каждого врача клиники

Горовая Наталья Сергеевна
кандидат медицинских наук врач высшей категории по ультразвуковой диагностике член Российской ассоциации специалистов ультразвуковой диагностики в медицине стаж работы более 25 лет.
Подробнее →
Калачева Ирина Васильевна
врач акушер-гинеколог оперирующий гинеколог гинеколог-эндокринолог эстетический гинеколог врач ультразвуковой диагностики
Подробнее →
Риганова Оксана Сергеевна
Коррекция дефицитных состояний Индивидуальный подбор IV терапии Снижение веса/ набор мышечной массы Дефицит тестостерона у мужчин и женщин, подбор гормональной заместительной терапии Антивозрастная терапия (anti-aging)
Подробнее →Оставить заявку
Администратор свяжется, подберёт удобное время и ответит на вопросы




